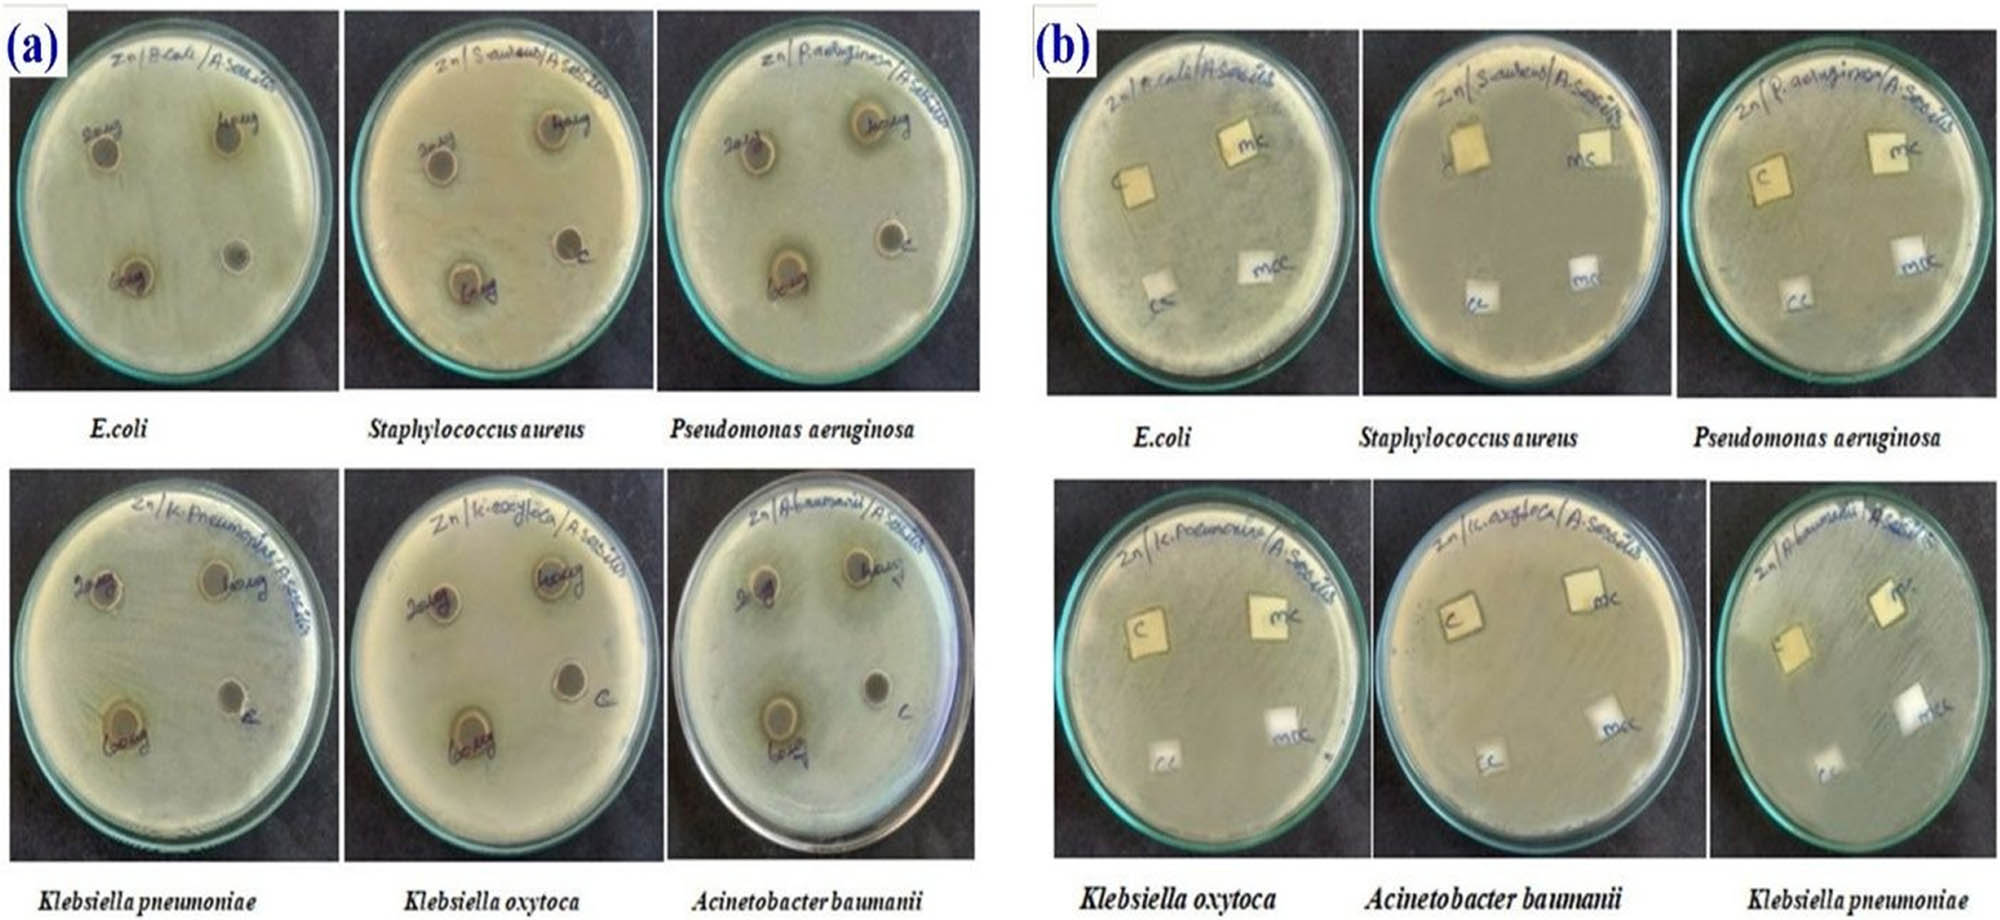

Embedding green synthesized zinc oxide nanoparticles in cotton fabrics and assessment of their antibacterial wound healing and cytotoxic properties: An eco-friendly approach
-
Nivedhitha Kabeerdass
and Maghimaa Mathanmohun
Abstract
This study explores the potential of the natural and cost-effective method of wound healing using Alternanthera sessilis by an in vitro study (using fibroblast L929 cells). Gram-positive bacteria Staphylococcus aureus shows a zone of inhibition of 20 mm at 60 µg concentration in the antibiogram profile against the zinc oxide nanoparticles (ZnONPs) wetted in fabrics synthesized from the Amaranthaceae family. Through characterization studies of the AS-ZnONPs, it was found that UV–visible spectra show a peak in the range of 350–460 nm, Fourier transform infrared spectroscopy spectra show a correlation peak in the range of 340–4,500 cm−1, scanning electron microscope with electron diffraction analysis results in a peak in the range of 7.8–9.4, and high-resolution transmission electron microscope, which exposes the morphological character (diamond shape in a black and white background), shows a peak at 200 nm. This work shows that the leaf extract of A. sessilis might support the ancient method of wound healing.
Abbreviations
- FT-IR
-
Fourier transform infrared spectroscopy
- HR-TEM
-
high-resolution transmission electron microscope
- MDR
-
multidrug resistant
- MHA
-
Muller–Hinton agar
- MRSA
-
methicillin resistant Staphylococcus aureus
- MTT
-
yellow tetrazolium salt (3-(4,5-dimethylthiazol-2-yl)-2,5-diphenyltetrazolium bromide)
- SEM with EDX
-
scanning electron microscope with electron diffraction analysis
- UV-Vis
-
UV-visible
- XDR
-
extreme drug resistant
1 Introduction
The distinctive properties of the nanoparticles and synthesis of innovative materials in nanosize put them at the forefront of science and technology [1]. Nanotechnology involves the manipulation of individual atoms and molecules. A nanoparticle is desirable because of its uniformity, conductivity, and optical property. Excitement was observed in nanotechnology by developing new materials that are applicable in the field of nanomedicine, energy production, and biomaterials. Green nanotechnology provides knowledge about the versatile pharmacological nature of rare plant species [2,3,4]. Alternatively, nanoparticles play a role as effective pesticides and control plant disease and increase crop production by acting as potent fertilizers. Using nanomembranes helps to remove biological and chemical components from polluted water. Phytonanotechnology is simple, rapid, eco-friendly, and biocompatible. By triggering valence electrons, zinc oxide nanoparticles (ZnONPs) generate reactive oxygen species and bring structural changes to cellular components such as ribosomes, Golgi bodies, bacterial cell membrane, and genetic material [5]. In the transport of drugs, it also serves as a biological carrier. The reduction of metal ions exploits the reduction of phytocompounds due to zero valency of the nanoparticles. It possesses multiple roles in antibacterial activities and in curing ulcers. Zinc oxide nanoparticles prevent bacterial growth in vitro and in vivo, accelerate wound closure, expose biocompatibility, and reduce cytotoxicity. The green synthesis of zinc oxide nanoparticles is cheap and eco-friendly, and zinc oxide nanoparticles are a novel alternative therapeutic agent for wound healing [6]. Alternanthera sessilis is a folklore medicine for treating various ailments. It belongs to Amaranthaceae and is a dwarf copper leaf or sessile joyweed. It is aprostrate perrinial herb. The leaves of A. sessilis contain β-sitosterolpalmalitate, nonacosane, 16-hentriacontane, handianol, and oxalic acid. The presence of α-tocopherol and β-tocopherol shows antimicrobial activity against Trichophyton mentagrophytes and Staphylococcus aureus [7,8]. The root and shoot have antihypertensive properties. The leaves possess medicinal properties to treat bronchitis and diarrhea and help to rejuvenate the skin. It also helps to treat inflamed wounds. It also bears another critical therapeutic role in treating liver disease-related gangrene. Catechin, ethyl gallate, ferulic acid, daidzein, and chlorogenic acid are effective bioactive constituents that act as a precursor in the anti-inflammatory, antimicrobial, and antiwound healing activities. Secondary metabolites or proteins in the plant extract act as a reducing and capping agent, which help to stabilize the formation of nanoparticles.
S. aureus is a common dangerous Gram-positive coccal-shaped bacterium. It causes pneumonia, heart valve infection, and bone infections. Sneezing enters the bloodstream and causes redness, blisters, and abscesses. S. aureus produces many toxins and causes toxic shock syndrome and food poisoning. Beta-lactam antibiotics show resistance to most strains of S. aureus. This was later entitled methicillin-resistant S. aureus. Antibiotics that show susceptibility to S. aureus are sulfamethoxazole, clindamycin, minocycline, and vancomycin [9]. A revolutionary technique used in cotton fabrics in recent years to expose their active surfaces with antimicrobial characteristics is nano-coating. An in vivo study showed enhanced solubility, efficacy, biocompatibility, and cytotoxic effect of synthesis on fibroblast L929 cells [10]. This cell line derived from the subcutaneous tissue of the mouse shows the features of cancer growth. Fibroblast cells contain all components of proteins, amino glycans, and proteoglycans. The multiple simultaneous roles of fibroblast, which are interwoven in fibrosis, are wound healing, angiogenesis, and inflammation [11]. In this study, we inspect the antibacterial potential and expose the wound healing efficacy of the aqueous extract of A. sessilis leaves mediated zinc oxide nanoparticles toward in the fibroblast L929 cells.
2 Materials and methods
2.1 Plant material collection and extract processing
A cheap, obovate copperleaf, with sessile spike flowers and viridescent perpetual herbs are plucked from the water canals in the surrounded area of Rasipuram [12]. Poststerilization techniques include separation of affected leaves, shadow drying, and pulverization [13]; then, 10 g of fresh leaves was immersed in 200 mL of MilliQ water in a 500 mL Erlenmeyer flask. Then, the solution was boiled at 70℃ for 10 min; the obtained solution was filtered using Whatman no. 1 filter paper and used for zinc oxide nanoparticle synthesis.
2.2 Metallic nanoparticle synthesis (zinc)
Zinc acetate is prepared for synthesis by dissolving 1 mM zinc acetate in 50 mL of MilliQ water, followed by stirring continuously for 1 h. Yellow color is obtained at 35°C after adding 20 mL of zinc acetate to 25 mL of the prepared plant extract solution (A. sessilis leaf extract) slowly [14]. Further purification is done by centrifuging the precipitate or residues several times in deionized water, and at last, calcined white crystals of zinc oxide nanoparticles are obtained. To remove water molecules, the crystals are kept in an oven at 60°C for 2 h. Finally, the obtained pellets are stored in an airtight container for further use.
2.3 Collection of commensals
Sterile and adequately sealed containers are filled with fresh, early morning voided sputum, midstream urine, pus-soaked swab with a rotten egg odor, blood- or mucus-covered stools, and infectious blood samples collected from the private hospitals and laboratories in Madurai by wearing aseptic gloves, a germ-free head cap, and an unsoiled labcoat. The swabs were aseptically handled by placing them in an appropriate medium; in the case of a blood sample, it is laid in EDTA to prevent clotting. Then, complete history of the patients, such as age, sex, and appearance of the sample, was noted clearly on the container using a marker pen [15,16]. To isolate the targeted species and prevent cross contamination, all the commensals were packed in a leak-proof container and placed in ice cubes for transportation.
2.4 Phenotype screening
The commensals are isolated in appropriate media like nutrient agar, McConkey agar, eosin methylene blue agar, and blood agar media in quadrants. The zig-zag method of streaking is performed on the appropriately labeled plate. After 24 h of incubation, a soft raised mucoid, off-white with wintergreen smell colonies is observed on the plate [17,18]. Then, its phenotypic characters are noted by preparing a smear, which is then rinsed with primary stain, mordant, acetone and safranin for a few minutes and, at last, wiped with the help of tissue paper and observed under a microscope to identify whether it is gram-positive or gram-negative isolates. The isolates are further confirmed by rinsing with solvents like methyl red, Kovacs reagent, and glucose broth by showing some color changes, which are collectively known as biochemical tests [19].
2.5 Bactericidal action
A well is created in the Muller–Hinton agar plate using a sterile cork borer of 6 mm, and the isolates were spread uniformly using a sterile cotton swab tip and incubated in an inverted position [20,21]. Forceps are used to remove the plugs in an aseptic manner. After emptying the crude zinc oxide nanoparticles in various concentrations (20, 40, and 60 µg) using a micropipette into each well, and without any disturbances, the plates are placed in an upright manner in an incubator.
2.6 Cotton sensitivity test
Cotton and mixed cotton cloth are cut into small pieces and soaked in the crude zinc oxide nanoparticles later on they are aseptically placed in the freshly prepared Muller–Hinton agar plate in which the isolates are spread evenly [22,23]. A plate labeled as control contains a piece of cotton and mixed cotton cloth that is free from nanoparticle extract.
2.7 Characterization study of zinc oxide nanoparticles coated on cotton
2.7.1 UV-Vis spectra
UV-Vis spectroscopy is a soft, analytical technique to identify the organic and inorganic compounds and also measure the absorbed light and express the derivatives of the solid or liquid nanomaterial in the form of wavelengths.
2.7.2 FT-IR
Fourier transform infrared (FT-IR) spectroscopy is a valuable tool that converts the detector output to an interpretable spectrum. It identifies the atom and bond arrangements within the organic molecule. Through the frequency and software in the spectroscopy, it is easy to identify the molecular and functional groups in the sample [24]. It helps to easily characterize the stability and variability of the various antioxidant properties in the sample.
2.7.3 SEM with EDAX
Scanning electron microscopy (SEM) describes the qualitative and quantitative analyses of the specimen with a peak magnification. Then, the samples in SEM are prepared by cutting them into thin slices using a microtome and rubbed on a coarse surface and cleansed using organic solvents [25]. Energy-dispersive X-ray spectrometers focus on the specimen by an array of electrons, and the X-ray signals fall on the specimen and obtain the composition of the elements present in the sample [24].
2.7.4 HR-TEM
The sample for a high-resolution transmission electron microscope (HR-TEM) is made into thin sections using a microtome and mounted on the slide, and the crystallographic structure of the specimen is obtained against the black and white surrounding [26].
2.7.5 Enrichment of collected cell lines
The cell lines were procured from the cell repository of the National Centre for Cell Sciences (NCCS), Pune, India. These were maintained in a humidified environment with 5% CO2 at 37°C and cultured in Dulbecco’s modified Eagle’s medium (DMEM), which was enhanced with 10% fetal bovine serum (FBS). Penicillin (100 U·mL−1) and streptomycin (100 μg·mL−1) acted as bactericidal agents.
2.7.6 L929 assay
Dulbecco’s modified Eagle’s medium consists of L929 cell lines and model nanoparticles (AS-ZnONPs) whose viability is branded after 24 h of incubation. Then, the reductase in cell lines reduces MTT (yellow 3-4,5dimethylthiozol-2-yl)-2,5diphenyltetrazoliumbromide) to formazan crystals by developing a purple color product; these crystals show absorbance at 570 nm in a microtitre plate after dissolving them in dimethylsulfoxide (DMSO) and are statistically analyzed.
2.7.7 Cell migration assay
About 1 × 104 cells·mL−1 are appropriately cultured at 37°C for a day in 24 wells. Then, a straight-line scratch is made using the tip of the micropipette (200 µL). Debris cells are washed clean two times using PBS. Then, the cells are mingled with different concentrations of AS-ZnONPs (5/15 µg) and maintained in the cell incubator for 5% CO2 at 37°C for 1.5 days (36 h). By using a fluorescent and electron microscope, the images of cells mingled with zinc oxide nanoparticles are captured at different time intervals and processed using the software.
3 Results and discussion
3.1 Metallic nanoparticle synthesis
After taking the dry weight of the leaf powder, they undergo heating with solid magnetic stirring for 1 h with zinc acetate, and bronze yellow solution at 35°C is obtained after treating with zinc acetate and stirring slowly [27]. Further purification is done, and the crystals of zinc oxide nanoparticles are obtained after calcination at 250°C for 4–5 h, in which the A. sessilis extract is added dropwise. The nontoxic nature and the presence of the biomolecules in the plant extract play an efficient role in reducing metals and act as a capping agent in the synthesis of zinc oxide nanoparticles, which is clearly explained and shown in Figure 1.

Graphical representation of green synthesis zinc oxide nanoparticle (AS-ZnONPs) coated fabrics for antibacterial wound healing potential and in vitro cytotoxic assessment using fibroblast L929 cells.
3.2 Isolated microbes
From different private hospitals and laboratories in Madurai, nearly 25 samples were isolated from the other age groups of patients in various sectors of the hospitals. About 7% of isolated strains from males in the dental ward, CCU, general ward, and ICU are Gram positive and Gram negative. The other 7% of strains isolated from females in the labor ward, CCU, ICU, and general ward are only Gram negative. The rest 6% of isolated strains from infants and children of ICU, CCU, general ward, and SOT are both Gram positive and Gram negative, and 1% are other commensals. A detailed explanation is given in Figure 2. Biochemical tests, which are other confirmatory tests for Gram-positive and Gram-negative organisms, show the positive sign for their respective isolates [28].

Collection of isolates from different wards. The number of isolates collected from various patient wards. Isolated Gram positive and Gram negative bacteria.
3.3 Bactericidal action
Among the isolated strains, the Gram-positive S. aureus shows an elevated zone of inhibition of 20 ± 0.577 mm at 60 µg concentration against the AS-ZnONPs. Gram negative E. coli (19 ± 0.577 mm), Klebsiella pneumoniae (18 ± 1.732 mm), Klebsiella oxytoca (17 ± 2.309 mm), and Acinetobacter baumanii (12 ± 1.732 mm) show less susceptibility than the Gram-positive organism. Vancomycin antibiotic showed a resistance and sensitivity pattern. A similar report on Lebbeck stem extract reveals that the Gram-positive bacteria S. aureus also shows a zone of inhibition of around 21 mm at 60 µg concentration, as presented in Table 1 and Figure 3a.
Antimicrobial activity of synthesized AS-ZnONPs and antibiotics against the isolates
Name of the organism | 20 µg | 40 µg | 60 µg | Vancomycin |
---|---|---|---|---|
E. coli | 16 ± 1.732 | 17 ± 2.309 | 18 ± 1.732 | 22 ± 2.887 |
S. aureus | 17 ± 2.309 | 18 ± 1.732 | 20 ± 0.577 | 7 ± 0.000 |
P. aeruginosa | 17 ± 2.309 | 19 ± 0.577 | 19 ± 0.577 | 18 ± 1.732 |
Klebsiella pneumoniae | 15 ± 1.155 | 16 ± 1.732 | 18 ± 1.732 | 07 ± 0.000 |
K. oxytoca | 13 ± 1.155 | 15 ± 1.155 | 17 ± 2.309 | 17 ± 2.309 |
A. baumanii | 11 ± 0.577 | 11 ± 0.577 | 12 ± 1.732 | 7 ± 0.000 |
(a) Antimicrobial activity of synthesized AS-ZnONPs against the isolates. (b) Antimicrobial sensitivity test of AS-ZnONPs coated fabrics against the isolates.
3.4 Cotton sensitivity test
Small square-shaped cotton fabric is wetted with zinc oxide nanoparticles [29]. S. aureus shows a minimal zone of inhibition of 18 ± 1.732 mm when compared with E. coli, K. pneumonia, K. oxytoca, and A. baumanii, which show minimal zone of inhibition of 18 ± 1.1732, 16 ± 1.732, 15 ± 1.155, and 14 ± 2.309 mm, respectively, in cotton fabric than in mixed cotton fabric. The results are briefly explained in Table 2 and Figure 3b.
Antimicrobial sensitivity test of AS-ZnONPs coated cotton fabrics against the isolates
S. no | Name of the organism | Mixed cotton fabric (ZOI) | Cotton fabric (ZOI) |
---|---|---|---|
1 | E. coli | 15 ± 1.155 | 18 ± 1.132 |
2 | S. aureus | 14 ± 2.309 | 18 ± 1.732 |
3 | P. aeruginosa | 15 ± 1.155 | 18 ± 1.732 |
4 | K. pneumoniae | 15 ± 1.155 | 16 ± 1.732 |
5 | K. oxytoca | 14 ± 2.309 | 15 ± 1.155 |
6 | A. baumanii | 13 ± 1.155 | 14 ± 2.309 |
3.5 Characterization study of zinc oxide nanoparticles coated on cotton
3.5.1 UV-Vis spectra
In UV-Vis spectra, the wavelength of the AS-ZnONPs [30] is observed in the range of 350–460 nm, which is shown clearly in Figure 4a.

(a) UV spectrum analysis of synthesized AS-ZnONPs 350–460 nm. (b) Spectrum of FT-IR analysis of synthesized AS-ZnONPs. (c) SEM with EDX analysis of AS-ZnONP-coated cotton fabric. (d) EDX with table energy dispersive X-ray the zinc shows a weight of 8.10% and shows a peak in the range of 7.8–9.1.
3.5.2 FT-IR
The presence of alkyl groups, ketones, flavonoids, terpenoids, and oxygen atoms is recorded in the peak lengths of 700, 1,200, 2,000, 2,900, and 3,500 cm−1, respectively; As-ZnONPs the potential characteristic narrow bands absorbed which represents its corresponding functional groups. The peak range is represented by the reduction of the ions by identifying their peaks with phyto compound in the aqueous extract of Acorus calamus rhizome of 500–3,554 cm−1 [19] aqueous extract of Limonia acidissima represents the peak range of 500–4,500 cm−1 [31] aqueous and methanol leaf extract of the Azadirachta indica represents its wave number in the range of 1,200–2,500 cm−1 for aqueous and in the case of ethanol extract, the slight changes observed in the shifting of the oxygen atoms from 1,550–1,700 cm−1 in FT-IR work a transmission peak is observed in the range of 340–4,700 cm−1. This bandwidth in AS-ZnONPs reveals the phytochemistry and surface chemistry of the nanoparticle, as shown in Figure 4b.
3.5.3 SEM with EDAX
AS—ZnONP-embedded cotton fabrics are viewed under SEM and energy-dispersive X-ray (EDX) spectroscopy with a width of 9.54 mm, and the images are obtained at a magnification of 433× and a scan speed of 4, as shown in Figure 4c [32]. The carbon weight is 47%, the oxygen and potassium weight is 44%, and the zinc weight is 8.1%, and energy-dispersive X-ray (EDX) spectra show a peak in the range of 7.8–9.4. The metal’s reflection and atomic mass are also shown in Figure 4d.
3.5.4 HR-TEM
A high-resolution transmission electron microscope (HR-TEM) investigates the 200-nm diamond-shaped zinc oxide nanoparticle embedded in the cotton fabric, and the image is taken by an LCD camera is given in Figure 5.

High-resolution transmission electron microscope of synthesized AS-ZnONPs.
3.5.5 Obtained biopsy vs AS-ZnONPs
The chemically extracted and sediment AS-ZnONPs were probed for their efficacy via the cells in connective tissue producing collagen and proteins. The specimens were soiled with AS-ZnONPs for 24 h at 27°C. Diapedising and crowding of histological and cytological ingredients toward the lesion floor denote the progressive prognosis, and healing toward keloid-free scar formation, which indicates this mechanism due to the adjunction of AS-ZnONPs (Figure 6a and b). The description and explanatory details of the histological practical performed with 2.5–10 µg of adjuncting AS-ZnONPs evidenced the cytological diapedesis, resulting in their massive accumulation (proliferation), which denotes wound healing than the control, as shown in Figure 7 and a detailed explanation of the efficacy of the synthesized AS-ZnONPs toward biopsy (L929 cell lines) and the elevated concentrations of AS-ZnONPs in the wound healing assay is also schematically represented in Figure 7a.

(a) Morphological changes in control and AS-ZnONPs treated Normal fibroblast L929 cells for 24 h. (a) Photomicrograph (20×) represents the morphology of AS-ZnONPs treated with L929 cells. (b) AS-ZnONPs treatment did not show any toxicity and cell changes to the L929 cells, assay. Various concentrations of synthesized zinc oxide nanoparticles and their mode of healing efficacy against human fibroblast (L929 cell line) are graphically explained.

(a) In vitro cell migration vs fabric coated phyto-mediated metal nanoparticles synthesis (wound healing). It reveals the minimal concentration (2.5 µg·mL−1) of mixed cotton-coated A. sessilis mediated zinc oxide nanoparticles show an elevated cell migration in wound scratch assay. (b) Effect of AS-ZnONPs on cell migration of L929 cells. Cell migration assay 2.5 and 5 µg·mL−1 of AS-ZnONps treated against human fibroblast cells for 24 h no changes were observed compared with control which proves it is non-toxic.
4 Discussion
The replacement of hormonal, gonadal, insane, and dependency faults is of broad therapeutic value. The therapeutic advantages of A. sessilis an all-seasonal habit and environment are gained by their pheno and geno personalities. As a result, the osmoregulation is fully satisfied with the provision of expected occurrences together with metals' invisible substances in extrinsic and intrinsic ways. Ionic exchanges are also crucial for precipitation because of this [22]. These micro and ultra-micro status is an important structural appearance innovating gifts for our beneficial expectations accession of the barrier boundaries by these invisible substances is the main criteria. This phenomenon values the products. This behavior triggers the inventors to concentrate on furthermore inventions. Avalanche, spread, accession, invasion, osmosis, bulging, bursting, atomic and ionic permeability, and invasion and elimination are all regulatory occurrences that end up resulting in the expectational target in the animalcules [16]. This process is processed by beneficial efforts emitting phytochemical botanical floral metallic (zinc) invisible micro and ultra-micro pharmacotherapies. Inventors materialize their healing efficacy through very many inventions. It is proved that in vitro diapedesis is not only progressive criteria but adjunction with the AS-ZnONPs metallic products evidence as to the rear repairing of the lesions through practical done in biopsy obtained. Updated based on their appropriate beneficial efforts thus their economic importance is probed. Accuracy, abundance, and abrupt availability is confirmed as artificial plant production provides discomfort. The same when an appeal to naturalists is very well economical and eco-friend and hazard-free expel [33]. The natural primary and secondary metabolites adjoin with innovative invisible substances to enhance the healing characteristics. The proliferative healthy cells imitate crowding. Dryness of the floor of the lesion indicates healing. Diabetes is directly proportional to progressive prognosis our Phyto therapeutic nanoparticles encourage and promote the above mechanism. This renders the fast healing. The obtained benefit is also cost-free, with hazard-free retiring in the health institutions restricted.
5 Conclusion
Wound healing naturally delays if it is not followed up carefully. Caretaking includes cleanliness and application of soothing curatives since epic era methods of soiling and covering the lesion with layers of healers. Later, the expectational emulsion contains ingredients that suppress the offensive secretions from the wet wound field and dry the wound, thus enhancing the repairing. This phenomenon is updated as the pharma preparations with botanical floral phytochemicals and metallic ultra-micro-nanoparticles repair the expectations before time, resulting in fruit fullness. Through an in vitro human fibroblast cell line study, which reflects the efficacy of the fabricated As–zinc oxide nanoparticle synthesis, it is proved that AS-ZnONP is a worthful nano wound healer and can fight and win the battle against any chronic ulcers and gangrenes caused by multidrug-resistant bacteria and extreme drug-resistant bacterial strains in the medical field (XDR).
Acknowledgments
The authors are thankful for the financial support from Member Secretary, Tamil Nadu State Council for Science and Technology (TNSCST), DOTE Campus, Chennai (Science and Technology Project: TNSCST/STP-PRG/AR/2018-2019), and DST–FIST Centralized laboratory, Muthayammal College of Arts and Science, Tamilnadu, India, for executing this work. The project was supported by Researchers Supporting Project number (RSP-2021/143), King Saud University, Riyadh, Saudi Arabia.
-
Funding information: The study was funded by Tamil Nadu State Council for Science and Technology (TNSCST), DOTE Campus, Chennai (Science and Technology Project: TNSCST/STP-PRG/AR/2018-2019), DST–FIST Centralized laboratory, Muthayammal College of Arts and Science, India, for executing this work.
-
Author contributions: Nivedhitha Kabeerdass, Selvankumar Thangasamy, and Karthikeyan Murugesan: conceptualization, investigation, supervision, formal analysis, methodology, validation, writing – original draft, and visualization; Natarajan Arumugam and Abdulrahman I. Almansour: investigation, methodology, validation, and writing – review and editing; Raju Suresh Kumar: project administration, visualization, and writing – review and editing; Plalanivel Velmurugan and Vinayagam Mohanavel: formal analysis, validation, and writing – review and editing; Selvaraj Vijayanand and Thajuddin Nooruddin: formal analysis, validation, resources, and writing – review and editing; Subpiramaniyam Sivakumar and Maghimaa Mathanmohun: data curation, formal analysis, validation, resources, writing – original draft: data curation, formal analysis, validation, resources, and writing – review and editing.
-
Conflict of interest: One of the authors (Palanivel Velmurugan) is a Guest Editor of the Green Processing and Synthesis’ Special Issue “Use of magnetic resonance in profiling bioactive metabolites and its applications” in which this article is published.
-
Data availability statement: The data used to support the findings of this study are included in the article. Should further data or information be required, these are available from the corresponding authors upon request.
References
[1] Vakayil R, Krishnamoorthy S, Kumar GS, Ramasamy NS, Mathanmohun M. Screening and identification of multi-drug resistance nosocomial infection, isolates from clinical specimen: a cross-sectional study. Plant Arch. 2020;20(2):7247–51.Search in Google Scholar
[2] Ansari S, Bari A, Ullah R, Mathanmohun M, Veeraraghavan VP, Sun Z. Gold nanoparticles synthesized with Smilax glabra rhizome modulates the anti-obesity parameters in high-fat diet and streptozotocin-induced obese diabetes rat model. J Photochem Photobiol B Biol. 2019;201:111643. 10.1016/j.jphotobiol.2019.111643.Search in Google Scholar PubMed
[3] Sun X, Veeraraghavan VP, Surapaneni KM, Hussain S, Mathanmohun M, Alharbi SA, et al. Eugenol–piperine loaded polyhydroxy butyrate/polyethylene glycol nanocomposite‐induced apoptosis and cell death in nasopharyngeal cancer (C666‐1) cells through the inhibition of the PI3K/AKT/mTOR signaling pathway. J Biochem Mol Toxicol. 2021 Apr;35(4):e22700.10.1002/jbt.22700Search in Google Scholar PubMed
[4] Fan Y, Maghimaa M, Chinnathambi A, Alharbi SA, Veeraraghavan VP, Mohan SK, et al. Tomentosin reduces behavior deficits and neuroinflammatory response in MPTP-induced Parkinson’s disease in mice. J Environ Pathol Toxicol Oncol. 2021;40(1):75–84.10.1615/JEnvironPatholToxicolOncol.v40.i1.70Search in Google Scholar PubMed
[5] Vakayil R, Kabeerdass N, Kuppusamy A, Mathanmohun M. Phytochemical screening and antibacterial properties of Punica granatum extracts against gastrointestinal infection an in-vitro study. Uttar Pradesh. J Zool. 2019;26:25–32.Search in Google Scholar
[6] Arya G, Kumari RM, Gupta N, Kumar A, Chandra R, Nimesh S. Green synthesis of silver nanoparticles using Prosopis juliflora bark extract: reaction optimization, antimicrobial and catalytic activities. Artif Cell Nanomed Biotechnol. 2018;46:985–93. 10.1080/21691401.2017.1354302.Search in Google Scholar PubMed
[7] Abirami K, Maghimaa M. Phytochemical screening and bioactivity of Zingiber Officinale to combat the multidrug-resistant bacterial pathogens using foldscope. Uttar Pradesh J Zool. 2019;11:67–74.Search in Google Scholar
[8] Baburam S, Ramasamy S, Shanmugam G, Mathanmohun M. Quorum sensing inhibitory potential and molecular docking studies of Phyllanthus emblica phytochemicals against pseudomonas aeruginosa. Appl Biochem Biotechnol. 2022;194(1):434–44.10.1007/s12010-021-03683-wSearch in Google Scholar PubMed
[9] Vakayil R, Kabeerdass N, Murugesan K, Shanmugam G, Ramasamy S, Mathanmohun M. Antibacterial activity and molecular characteristics of Indian Olibanum (Boswellia serrata) Phytochemicals: An In Silico Approach. Appl Ecol Environ Res. 2022;20(2):919–29.10.15666/aeer/2002_919929Search in Google Scholar
[10] Amreddy N, Babu A, Muralidharan R, Panneerselvam J, Srivastava A, Ahmed R, et al. 2018. Recent advances in nanoparticle-based cancer drug and gene delivery. Adv Cancer Res. 2018;137:115–70.10.1016/bs.acr.2017.11.003Search in Google Scholar PubMed PubMed Central
[11] Deshmukh SK, Srivastava SK, Poosarla T, Dyess DL, Holliday NP, Singh AP, et al. Inflammation, immunosuppressive microenvironment and breast cancer: opportunities for cancer prevention and therapy. Ann Transl Med. 2019;7(20):593.10.21037/atm.2019.09.68Search in Google Scholar PubMed PubMed Central
[12] Govindasamy S, Thirumarimurugan M, Muthukumaran C. Green synthesis of ZnO nanoparticles using Tecoma castanifolia leaf extract characterization and evaluation of its antioxidant bactericidal and anticancer activities. Microchem J. 2019;145:578–87. 10.1016/j.microc.2018.11.022.Search in Google Scholar
[13] Vakayil R, Krishnamoorthy S, Anbazhagan M, Kumar NS, Mathanmohun M. Antibacterial potential of acorus calamus extracts against the multi-drug resistant nosocomial pathogens. Uttar Pradesh J Zool. 2021;24:144–50.Search in Google Scholar
[14] Gnanasekar S, Murugaraj J, Dhivyabharathi B, Krishnamoorthy V, Jha PK, Seetharaman P, et al. Antibacterial and cytotoxicity effects of biogenic palladium nanoparticles synthesized using fruit extract of Couroupita guianensis Aubl. J Appl Biomed. 2018;16:59–65. 10.1016/j.jab.2017.10.001.Search in Google Scholar
[15] Al-Asfar A, Zaheers Z, Aazam ES. Eco-friendly green synthesis of Ag@Fe bimetallic nanoparticles: antioxidant, antimicrobial and photocatalytic degradation of bromothymol blue. J Photochem Photobiol B Biol. 2018;185:143–52. 10.1016/j.jphotobiol.2018.05.028.Search in Google Scholar PubMed
[16] Vakayil R, Abdul Nazeer T, Mathanmohun M. Evaluation of the antimicrobial activity of extracts from Acorus calamus rhizome against multidrug-resistant nosocomial pathogens. Res J Agric Sci. 2021;12(5):1613–7.Search in Google Scholar
[17] Dobrucka R, Dlugaszewska J. Antimicrobial activity of the biogenically Synthesized core-shell Cu@Pt nanoparticles. Saudi Pharm J. 2018;26:643–50. 10.1016/j.jsps.2018.02.02.Search in Google Scholar
[18] Kabeerdass N, Krishnamoorthy S, Anbazhagan M, Srinivasan R, Nachimuthu S, Rajendran M, et al. Screening, detection and antimicrobial susceptibility of multi-drug-resistant pathogens from the clinical specimens. Mater Today Proc. 2021;47:461–7. 10.1016/j.matpr.2021.05.018.Search in Google Scholar
[19] Vakayil R, Muruganantham S, Kabeerdass N, Rajendran M, Ramasamy S, Alahmadi TA, et al. Acorus calamus-zinc oxide nanoparticle coated cotton fabrics shows antimicrobial and cytotoxic activities against skin cancer cells. Process Biochem. 2021 Aug 25;111:1–8. 10.1016/j.procbio.2021.08.024.Search in Google Scholar
[20] Gopinath V, Priyadarshini S, Ali DM, Loke MF, Thajuddin N, Alharbi NS, et al. Anti-Helicobacter pylori, cytotoxicity and catalytic activity of biosynthesized gold nanoparticles: multifaceted application. Arab J Chem. 2019;12:33–40. 10.1016/j.arabjc.2016.02.005.Search in Google Scholar
[21] Vakayil R, Kabeerdass N, Srinivasan R, Shanmugam G, Ramasamy S, Mathanmohun M. Invitro and insilico study on antibacterial potentials of phytochemical extracts. Mater Today: Proc. 2021;47:2021–460. 10.1016/j.matpr.2021.05.017.Search in Google Scholar
[22] Jayakar V, Lokapur V, Shantaram M. Identification of the volatile bioactive compounds by GC-MS analysis from the leaf extracts of Garcinia cambogia and Garcinia indica. Med Plants-Int J Phytomed Relat Ind. 2020;12(4):580–90. 10.5958/0975-6892.2020.00070.2.Search in Google Scholar
[23] Maghimaa M, Alharbi SA. Green synthesis of silver nanoparticles from Curcuma longa L. and coating on the cotton fabrics for antimicrobial applications and wound healing activity. J Photochem Photobiol B Biol. 2020;204:111806. 10.1016/j.jphotobiol.2020.111806.Search in Google Scholar PubMed
[24] Vakayil R, Anbazhagan M, Shanmugam G, Ramasamy S, Mathanmohun M. Molecular docking and in vitro analysis of phytoextracts from B. serrata for antibacterial activities. Bioinformation. 2021;17(7):667–72. 10.6026/97320630017667.Search in Google Scholar PubMed PubMed Central
[25] Móricz ÁM, Lapat V, Morlock GE, Ott PG. High-performance thin-layer chromatography hyphenated to high-performance liquid chromatography-diode array detection-mass spectrometry for characterization of coeluting isomers. Talanta. 2020;219:121306. 10.1016/j.talanta.2020.121306.Search in Google Scholar PubMed
[26] Agatonovic-Kustrin S, Kustrin E, Gegechkori V, Morton DW. Bioassay-guided identification of α-amylase inhibitors in herbal extracts. J Chromatogr A. 2020;1620:460970.10.1016/j.chroma.2020.460970Search in Google Scholar PubMed
[27] Lokapur V, Jayakar V, Shantaram M. Preliminary phytochemical screening, physicochemical analysis and in-vitro antioxidant activity of selected Holigarna species- Endemic plant species of Western Ghats. Biomedicine. 2020;40(4):460–6. 10.51248/.v40i4.319.Search in Google Scholar
[28] Khiralla GM, El-Deeb BA. Antimicrobial and antibiofilm effects of selenium nanoparticles on some foodborne pathogens. LWT Food Sc Technol. 2015;63:1001–7. 10.1016/j.lwt.2015.03.086.Search in Google Scholar
[29] Ngoepe NM, Mbita Z, Mathipa M, Mketo N, Ntsendwana B, Hintsho-Mbita NC. Biogenic synthesis of ZnO nanoparticles using Monsonia burkenea for use in photocatalytic antibacterial and anticancer applications. Ceram Int. 2018;44:16999–7006. 10.1016/J.CERAMINT.2018.06.142.Search in Google Scholar
[30] Neethu S, Midhun SJ, Radhakrishnan EK, Jyothis M. Green synthesized Silver nanoparticles by marine endophytic fungus Penicillium polonicum and its antibacterial efficacy against biofilm forming multidrug-resistant Acinetobacter baumanii. Microb Pathog. 2018;116:263–72. 10.1016/j.micpath.2018.01.033.Search in Google Scholar PubMed
[31] Kabeerdass N, Kandasamy S, Albasher G, Alamri O, Alsultan N, Thangaswamy S, et al. Limonia acidissima leaf mediated gold nanoparticles synthesis and their antimicrobial and wound healing properties. Mater Lett. 2022;314:131893.10.1016/j.matlet.2022.131893Search in Google Scholar
[32] Tahir K, Nazir S, Ahmad A, LiB Khan AU, Khan ZUH, Khan FU, et al. Facile and green synthesis of phytochemicals capped platinum nanoparticles and in vitro their superior antibacterial activity. J Photochem Photobiol B. 2017;166:246–51. 10.1016/j.jphotobiol.2016.12.016.Search in Google Scholar PubMed
[33] Yadav N, Jaiswal AK, Dey KK, YadavVB, Nath G, Srivastava AK, et al. Trimetallic Au/Pt/Ag based nanofluid for an enhanced antibacterial response. Mater Chem Phys. 2018;218:10–7. 10.1016/j.matchemphys.2018.07.016.Search in Google Scholar
© 2022 Nivedhitha Kabeerdass et al., published by De Gruyter
This work is licensed under the Creative Commons Attribution 4.0 International License.
Articles in the same Issue
- Research Articles
- Kinetic study on the reaction between Incoloy 825 alloy and low-fluoride slag for electroslag remelting
- Black pepper (Piper nigrum) fruit-based gold nanoparticles (BP-AuNPs): Synthesis, characterization, biological activities, and catalytic applications – A green approach
- Protective role of foliar application of green-synthesized silver nanoparticles against wheat stripe rust disease caused by Puccinia striiformis
- Effects of nitrogen and phosphorus on Microcystis aeruginosa growth and microcystin production
- Efficient degradation of methyl orange and methylene blue in aqueous solution using a novel Fenton-like catalyst of CuCo-ZIFs
- Synthesis of biological base oils by a green process
- Efficient pilot-scale synthesis of the key cefonicid intermediate at room temperature
- Synthesis and characterization of noble metal/metal oxide nanoparticles and their potential antidiabetic effect on biochemical parameters and wound healing
- Regioselectivity in the reaction of 5-amino-3-anilino-1H-pyrazole-4-carbonitrile with cinnamonitriles and enaminones: Synthesis of functionally substituted pyrazolo[1,5-a]pyrimidine derivatives
- A numerical study on the in-nozzle cavitating flow and near-field atomization of cylindrical, V-type, and Y-type intersecting hole nozzles using the LES-VOF method
- Synthesis and characterization of Ce-doped TiO2 nanoparticles and their enhanced anticancer activity in Y79 retinoblastoma cancer cells
- Aspects of the physiochemical properties of SARS-CoV-2 to prevent S-protein receptor binding using Arabic gum
- Sonochemical synthesis of protein microcapsules loaded with traditional Chinese herb extracts
- MW-assisted hydrolysis of phosphinates in the presence of PTSA as the catalyst, and as a MW absorber
- Fabrication of silicotungstic acid immobilized on Ce-based MOF and embedded in Zr-based MOF matrix for green fatty acid esterification
- Superior photocatalytic degradation performance for gaseous toluene by 3D g-C3N4-reduced graphene oxide gels
- Catalytic performance of Na/Ca-based fluxes for coal char gasification
- Slow pyrolysis of waste navel orange peels with metal oxide catalysts to produce high-grade bio-oil
- Development and butyrylcholinesterase/monoamine oxidase inhibition potential of PVA-Berberis lycium nanofibers
- Influence of biosynthesized silver nanoparticles using red alga Corallina elongata on broiler chicks’ performance
- Green synthesis, characterization, cytotoxicity, and antimicrobial activity of iron oxide nanoparticles using Nigella sativa seed extract
- Vitamin supplements enhance Spirulina platensis biomass and phytochemical contents
- Malachite green dye removal using ceramsite-supported nanoscale zero-valent iron in a fixed-bed reactor
- Green synthesis of manganese-doped superparamagnetic iron oxide nanoparticles for the effective removal of Pb(ii) from aqueous solutions
- Desalination technology for energy-efficient and low-cost water production: A bibliometric analysis
- Biological fabrication of zinc oxide nanoparticles from Nepeta cataria potentially produces apoptosis through inhibition of proliferative markers in ovarian cancer
- Effect of stabilizers on Mn ZnSe quantum dots synthesized by using green method
- Calcium oxide addition and ultrasonic pretreatment-assisted hydrothermal carbonization of granatum for adsorption of lead
- Fe3O4@SiO2 nanoflakes synthesized using biogenic silica from Salacca zalacca leaf ash and the mechanistic insight into adsorption and photocatalytic wet peroxidation of dye
- Facile route of synthesis of silver nanoparticles templated bacterial cellulose, characterization, and its antibacterial application
- Synergistic in vitro anticancer actions of decorated selenium nanoparticles with fucoidan/Reishi extract against colorectal adenocarcinoma cells
- Preparation of the micro-size flake silver powders by using a micro-jet reactor
- Effect of direct coal liquefaction residue on the properties of fine blue-coke-based activated coke
- Integration of microwave co-torrefaction with helical lift for pellet fuel production
- Cytotoxicity of green-synthesized silver nanoparticles by Adansonia digitata fruit extract against HTC116 and SW480 human colon cancer cell lines
- Optimization of biochar preparation process and carbon sequestration effect of pruned wolfberry branches
- Anticancer potential of biogenic silver nanoparticles using the stem extract of Commiphora gileadensis against human colon cancer cells
- Fabrication and characterization of lysine hydrochloride Cu(ii) complexes and their potential for bombing bacterial resistance
- First report of biocellulose production by an indigenous yeast, Pichia kudriavzevii USM-YBP2
- Biosynthesis and characterization of silver nanoparticles prepared using seeds of Sisymbrium irio and evaluation of their antifungal and cytotoxic activities
- Synthesis, characterization, and photocatalysis of a rare-earth cerium/silver/zinc oxide inorganic nanocomposite
- Developing a plastic cycle toward circular economy practice
- Fabrication of CsPb1−xMnxBr3−2xCl2x (x = 0–0.5) quantum dots for near UV photodetector application
- Anti-colon cancer activities of green-synthesized Moringa oleifera–AgNPs against human colon cancer cells
- Phosphorus removal from aqueous solution by adsorption using wetland-based biochar: Batch experiment
- A low-cost and eco-friendly fabrication of an MCDI-utilized PVA/SSA/GA cation exchange membrane
- Synthesis, microstructure, and phase transition characteristics of Gd/Nd-doped nano VO2 powders
- Biomediated synthesis of ZnO quantum dots decorated attapulgite nanocomposites for improved antibacterial properties
- Preparation of metal–organic frameworks by microwave-assisted ball milling for the removal of CR from wastewater
- A green approach in the biological base oil process
- A cost-effective and eco-friendly biosorption technology for complete removal of nickel ions from an aqueous solution: Optimization of process variables
- Protective role of Spirulina platensis liquid extract against salinity stress effects on Triticum aestivum L.
- Comprehensive physical and chemical characterization highlights the uniqueness of enzymatic gelatin in terms of surface properties
- Effectiveness of different accelerated green synthesis methods in zinc oxide nanoparticles using red pepper extract: Synthesis and characterization
- Blueprinting morpho-anatomical episodes via green silver nanoparticles foliation
- A numerical study on the effects of bowl and nozzle geometry on performances of an engine fueled with diesel or bio-diesel fuels
- Liquid-phase hydrogenation of carbon tetrachloride catalyzed by three-dimensional graphene-supported palladium catalyst
- The catalytic performance of acid-modified Hβ molecular sieves for environmentally friendly acylation of 2-methylnaphthalene
- A study of the precipitation of cerium oxide synthesized from rare earth sources used as the catalyst for biodiesel production
- Larvicidal potential of Cipadessa baccifera leaf extract-synthesized zinc nanoparticles against three major mosquito vectors
- Fabrication of green nanoinsecticides from agri-waste of corn silk and its larvicidal and antibiofilm properties
- Palladium-mediated base-free and solvent-free synthesis of aromatic azo compounds from anilines catalyzed by copper acetate
- Study on the functionalization of activated carbon and the effect of binder toward capacitive deionization application
- Co-chlorination of low-density polyethylene in paraffin: An intensified green process alternative to conventional solvent-based chlorination
- Antioxidant and photocatalytic properties of zinc oxide nanoparticles phyto-fabricated using the aqueous leaf extract of Sida acuta
- Recovery of cobalt from spent lithium-ion battery cathode materials by using choline chloride-based deep eutectic solvent
- Synthesis of insoluble sulfur and development of green technology based on Aspen Plus simulation
- Photodegradation of methyl orange under solar irradiation on Fe-doped ZnO nanoparticles synthesized using wild olive leaf extract
- A facile and universal method to purify silica from natural sand
- Green synthesis of silver nanoparticles using Atalantia monophylla: A potential eco-friendly agent for controlling blood-sucking vectors
- Endophytic bacterial strain, Brevibacillus brevis-mediated green synthesis of copper oxide nanoparticles, characterization, antifungal, in vitro cytotoxicity, and larvicidal activity
- Off-gas detection and treatment for green air-plasma process
- Ultrasonic-assisted food grade nanoemulsion preparation from clove bud essential oil and evaluation of its antioxidant and antibacterial activity
- Construction of mercury ion fluorescence system in water samples and art materials and fluorescence detection method for rhodamine B derivatives
- Hydroxyapatite/TPU/PLA nanocomposites: Morphological, dynamic-mechanical, and thermal study
- Potential of anaerobic co-digestion of acidic fruit processing waste and waste-activated sludge for biogas production
- Synthesis and characterization of ZnO–TiO2–chitosan–escin metallic nanocomposites: Evaluation of their antimicrobial and anticancer activities
- Nitrogen removal characteristics of wet–dry alternative constructed wetlands
- Structural properties and reactivity variations of wheat straw char catalysts in volatile reforming
- Microfluidic plasma: Novel process intensification strategy
- Antibacterial and photocatalytic activity of visible-light-induced synthesized gold nanoparticles by using Lantana camara flower extract
- Antimicrobial edible materials via nano-modifications for food safety applications
- Biosynthesis of nano-curcumin/nano-selenium composite and their potentialities as bactericides against fish-borne pathogens
- Exploring the effect of silver nanoparticles on gene expression in colon cancer cell line HCT116
- Chemical synthesis, characterization, and dose optimization of chitosan-based nanoparticles of clodinofop propargyl and fenoxaprop-p-ethyl for management of Phalaris minor (little seed canary grass): First report
- Double [3 + 2] cycloadditions for diastereoselective synthesis of spirooxindole pyrrolizidines
- Green synthesis of silver nanoparticles and their antibacterial activities
- Review Articles
- A comprehensive review on green synthesis of titanium dioxide nanoparticles and their diverse biomedical applications
- Applications of polyaniline-impregnated silica gel-based nanocomposites in wastewater treatment as an efficient adsorbent of some important organic dyes
- Green synthesis of nano-propolis and nanoparticles (Se and Ag) from ethanolic extract of propolis, their biochemical characterization: A review
- Advances in novel activation methods to perform green organic synthesis using recyclable heteropolyacid catalysis
- Limitations of nanomaterials insights in green chemistry sustainable route: Review on novel applications
- Special Issue: Use of magnetic resonance in profiling bioactive metabolites and its applications (Guest Editors: Plalanoivel Velmurugan et al.)
- Stomach-affecting intestinal parasites as a precursor model of Pheretima posthuma treated with anthelmintic drug from Dodonaea viscosa Linn.
- Anti-asthmatic activity of Saudi herbal composites from plants Bacopa monnieri and Euphorbia hirta on Guinea pigs
- Embedding green synthesized zinc oxide nanoparticles in cotton fabrics and assessment of their antibacterial wound healing and cytotoxic properties: An eco-friendly approach
- Synthetic pathway of 2-fluoro-N,N-diphenylbenzamide with opto-electrical properties: NMR, FT-IR, UV-Vis spectroscopic, and DFT computational studies of the first-order nonlinear optical organic single crystal
Articles in the same Issue
- Research Articles
- Kinetic study on the reaction between Incoloy 825 alloy and low-fluoride slag for electroslag remelting
- Black pepper (Piper nigrum) fruit-based gold nanoparticles (BP-AuNPs): Synthesis, characterization, biological activities, and catalytic applications – A green approach
- Protective role of foliar application of green-synthesized silver nanoparticles against wheat stripe rust disease caused by Puccinia striiformis
- Effects of nitrogen and phosphorus on Microcystis aeruginosa growth and microcystin production
- Efficient degradation of methyl orange and methylene blue in aqueous solution using a novel Fenton-like catalyst of CuCo-ZIFs
- Synthesis of biological base oils by a green process
- Efficient pilot-scale synthesis of the key cefonicid intermediate at room temperature
- Synthesis and characterization of noble metal/metal oxide nanoparticles and their potential antidiabetic effect on biochemical parameters and wound healing
- Regioselectivity in the reaction of 5-amino-3-anilino-1H-pyrazole-4-carbonitrile with cinnamonitriles and enaminones: Synthesis of functionally substituted pyrazolo[1,5-a]pyrimidine derivatives
- A numerical study on the in-nozzle cavitating flow and near-field atomization of cylindrical, V-type, and Y-type intersecting hole nozzles using the LES-VOF method
- Synthesis and characterization of Ce-doped TiO2 nanoparticles and their enhanced anticancer activity in Y79 retinoblastoma cancer cells
- Aspects of the physiochemical properties of SARS-CoV-2 to prevent S-protein receptor binding using Arabic gum
- Sonochemical synthesis of protein microcapsules loaded with traditional Chinese herb extracts
- MW-assisted hydrolysis of phosphinates in the presence of PTSA as the catalyst, and as a MW absorber
- Fabrication of silicotungstic acid immobilized on Ce-based MOF and embedded in Zr-based MOF matrix for green fatty acid esterification
- Superior photocatalytic degradation performance for gaseous toluene by 3D g-C3N4-reduced graphene oxide gels
- Catalytic performance of Na/Ca-based fluxes for coal char gasification
- Slow pyrolysis of waste navel orange peels with metal oxide catalysts to produce high-grade bio-oil
- Development and butyrylcholinesterase/monoamine oxidase inhibition potential of PVA-Berberis lycium nanofibers
- Influence of biosynthesized silver nanoparticles using red alga Corallina elongata on broiler chicks’ performance
- Green synthesis, characterization, cytotoxicity, and antimicrobial activity of iron oxide nanoparticles using Nigella sativa seed extract
- Vitamin supplements enhance Spirulina platensis biomass and phytochemical contents
- Malachite green dye removal using ceramsite-supported nanoscale zero-valent iron in a fixed-bed reactor
- Green synthesis of manganese-doped superparamagnetic iron oxide nanoparticles for the effective removal of Pb(ii) from aqueous solutions
- Desalination technology for energy-efficient and low-cost water production: A bibliometric analysis
- Biological fabrication of zinc oxide nanoparticles from Nepeta cataria potentially produces apoptosis through inhibition of proliferative markers in ovarian cancer
- Effect of stabilizers on Mn ZnSe quantum dots synthesized by using green method
- Calcium oxide addition and ultrasonic pretreatment-assisted hydrothermal carbonization of granatum for adsorption of lead
- Fe3O4@SiO2 nanoflakes synthesized using biogenic silica from Salacca zalacca leaf ash and the mechanistic insight into adsorption and photocatalytic wet peroxidation of dye
- Facile route of synthesis of silver nanoparticles templated bacterial cellulose, characterization, and its antibacterial application
- Synergistic in vitro anticancer actions of decorated selenium nanoparticles with fucoidan/Reishi extract against colorectal adenocarcinoma cells
- Preparation of the micro-size flake silver powders by using a micro-jet reactor
- Effect of direct coal liquefaction residue on the properties of fine blue-coke-based activated coke
- Integration of microwave co-torrefaction with helical lift for pellet fuel production
- Cytotoxicity of green-synthesized silver nanoparticles by Adansonia digitata fruit extract against HTC116 and SW480 human colon cancer cell lines
- Optimization of biochar preparation process and carbon sequestration effect of pruned wolfberry branches
- Anticancer potential of biogenic silver nanoparticles using the stem extract of Commiphora gileadensis against human colon cancer cells
- Fabrication and characterization of lysine hydrochloride Cu(ii) complexes and their potential for bombing bacterial resistance
- First report of biocellulose production by an indigenous yeast, Pichia kudriavzevii USM-YBP2
- Biosynthesis and characterization of silver nanoparticles prepared using seeds of Sisymbrium irio and evaluation of their antifungal and cytotoxic activities
- Synthesis, characterization, and photocatalysis of a rare-earth cerium/silver/zinc oxide inorganic nanocomposite
- Developing a plastic cycle toward circular economy practice
- Fabrication of CsPb1−xMnxBr3−2xCl2x (x = 0–0.5) quantum dots for near UV photodetector application
- Anti-colon cancer activities of green-synthesized Moringa oleifera–AgNPs against human colon cancer cells
- Phosphorus removal from aqueous solution by adsorption using wetland-based biochar: Batch experiment
- A low-cost and eco-friendly fabrication of an MCDI-utilized PVA/SSA/GA cation exchange membrane
- Synthesis, microstructure, and phase transition characteristics of Gd/Nd-doped nano VO2 powders
- Biomediated synthesis of ZnO quantum dots decorated attapulgite nanocomposites for improved antibacterial properties
- Preparation of metal–organic frameworks by microwave-assisted ball milling for the removal of CR from wastewater
- A green approach in the biological base oil process
- A cost-effective and eco-friendly biosorption technology for complete removal of nickel ions from an aqueous solution: Optimization of process variables
- Protective role of Spirulina platensis liquid extract against salinity stress effects on Triticum aestivum L.
- Comprehensive physical and chemical characterization highlights the uniqueness of enzymatic gelatin in terms of surface properties
- Effectiveness of different accelerated green synthesis methods in zinc oxide nanoparticles using red pepper extract: Synthesis and characterization
- Blueprinting morpho-anatomical episodes via green silver nanoparticles foliation
- A numerical study on the effects of bowl and nozzle geometry on performances of an engine fueled with diesel or bio-diesel fuels
- Liquid-phase hydrogenation of carbon tetrachloride catalyzed by three-dimensional graphene-supported palladium catalyst
- The catalytic performance of acid-modified Hβ molecular sieves for environmentally friendly acylation of 2-methylnaphthalene
- A study of the precipitation of cerium oxide synthesized from rare earth sources used as the catalyst for biodiesel production
- Larvicidal potential of Cipadessa baccifera leaf extract-synthesized zinc nanoparticles against three major mosquito vectors
- Fabrication of green nanoinsecticides from agri-waste of corn silk and its larvicidal and antibiofilm properties
- Palladium-mediated base-free and solvent-free synthesis of aromatic azo compounds from anilines catalyzed by copper acetate
- Study on the functionalization of activated carbon and the effect of binder toward capacitive deionization application
- Co-chlorination of low-density polyethylene in paraffin: An intensified green process alternative to conventional solvent-based chlorination
- Antioxidant and photocatalytic properties of zinc oxide nanoparticles phyto-fabricated using the aqueous leaf extract of Sida acuta
- Recovery of cobalt from spent lithium-ion battery cathode materials by using choline chloride-based deep eutectic solvent
- Synthesis of insoluble sulfur and development of green technology based on Aspen Plus simulation
- Photodegradation of methyl orange under solar irradiation on Fe-doped ZnO nanoparticles synthesized using wild olive leaf extract
- A facile and universal method to purify silica from natural sand
- Green synthesis of silver nanoparticles using Atalantia monophylla: A potential eco-friendly agent for controlling blood-sucking vectors
- Endophytic bacterial strain, Brevibacillus brevis-mediated green synthesis of copper oxide nanoparticles, characterization, antifungal, in vitro cytotoxicity, and larvicidal activity
- Off-gas detection and treatment for green air-plasma process
- Ultrasonic-assisted food grade nanoemulsion preparation from clove bud essential oil and evaluation of its antioxidant and antibacterial activity
- Construction of mercury ion fluorescence system in water samples and art materials and fluorescence detection method for rhodamine B derivatives
- Hydroxyapatite/TPU/PLA nanocomposites: Morphological, dynamic-mechanical, and thermal study
- Potential of anaerobic co-digestion of acidic fruit processing waste and waste-activated sludge for biogas production
- Synthesis and characterization of ZnO–TiO2–chitosan–escin metallic nanocomposites: Evaluation of their antimicrobial and anticancer activities
- Nitrogen removal characteristics of wet–dry alternative constructed wetlands
- Structural properties and reactivity variations of wheat straw char catalysts in volatile reforming
- Microfluidic plasma: Novel process intensification strategy
- Antibacterial and photocatalytic activity of visible-light-induced synthesized gold nanoparticles by using Lantana camara flower extract
- Antimicrobial edible materials via nano-modifications for food safety applications
- Biosynthesis of nano-curcumin/nano-selenium composite and their potentialities as bactericides against fish-borne pathogens
- Exploring the effect of silver nanoparticles on gene expression in colon cancer cell line HCT116
- Chemical synthesis, characterization, and dose optimization of chitosan-based nanoparticles of clodinofop propargyl and fenoxaprop-p-ethyl for management of Phalaris minor (little seed canary grass): First report
- Double [3 + 2] cycloadditions for diastereoselective synthesis of spirooxindole pyrrolizidines
- Green synthesis of silver nanoparticles and their antibacterial activities
- Review Articles
- A comprehensive review on green synthesis of titanium dioxide nanoparticles and their diverse biomedical applications
- Applications of polyaniline-impregnated silica gel-based nanocomposites in wastewater treatment as an efficient adsorbent of some important organic dyes
- Green synthesis of nano-propolis and nanoparticles (Se and Ag) from ethanolic extract of propolis, their biochemical characterization: A review
- Advances in novel activation methods to perform green organic synthesis using recyclable heteropolyacid catalysis
- Limitations of nanomaterials insights in green chemistry sustainable route: Review on novel applications
- Special Issue: Use of magnetic resonance in profiling bioactive metabolites and its applications (Guest Editors: Plalanoivel Velmurugan et al.)
- Stomach-affecting intestinal parasites as a precursor model of Pheretima posthuma treated with anthelmintic drug from Dodonaea viscosa Linn.
- Anti-asthmatic activity of Saudi herbal composites from plants Bacopa monnieri and Euphorbia hirta on Guinea pigs
- Embedding green synthesized zinc oxide nanoparticles in cotton fabrics and assessment of their antibacterial wound healing and cytotoxic properties: An eco-friendly approach
- Synthetic pathway of 2-fluoro-N,N-diphenylbenzamide with opto-electrical properties: NMR, FT-IR, UV-Vis spectroscopic, and DFT computational studies of the first-order nonlinear optical organic single crystal